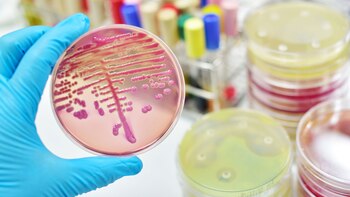
Es estudio comprobó que las

El hombre tiene la capacidad del sentido del tacto gracias a pequeños impulsos eléctricos que se transmiten de manera regular al cerebro. Recientemente expertos de la Universidad de Colorado (CU) en Boulder descubrieron que las bacterias, al igual que los seres humanos, tiene la capacidad de sentir el ambiente de una manera similar.
Hasta hoy se sabía sobre su particular reacción a ciertas señales químicas, por ejemplo al enfrentarse al azúcar o si se las exponía a un superficie rígida o blanda. Ahora la ciencia comprobó su singular reacción ante varios estímulos externos. Los hallazgos, podrían ser un gran avance en la investigación de bacterias y eventualmente ayudar al desarrollo de fármacos para enfermedades infecciosas.

El estudio fue publicado en la revista Proceedings de la Academia Nacional de Ciencias. El desarrollo consistió en insertar genes especiales en bacterias de E. coli que brillan cuando los iones de calcio o la electricidad pulsan a través de ellos. Las células se colocaron en un sustrato pegajoso bajo un microscopio. Una vez solas y sin estímulos, las células permanecieron oscuras, sin embargo cuando los científicos empujaron una almohadilla contra ellos, las bacterias se iluminaron. Las chispas de luz indicaron que las proteínas, los iones y la electricidad se movían alrededor de las bacterias.
"Lo que pensamos que podría estar sucediendo es que están utilizando estas señales eléctricas para modificar su estilo de vida", aseguró Joel Kralj, autor principal del estudio y profesor asistente en MCDB y BioFrontiers Institute .
Los expertos llegaron a concluir que los orígenes del sistema neuronal humano desde una perspectiva evolutiva se remontarían a "miles de millones de años", ya que claramente están presentes entre los organismos más antiguos del planeta según indican los resultados del estudio.

A su vez, se demuestra que la "herramienta común" podría usarse mismo en contra de las bacterias, ya que esta particularidad les permite a ciertas organismos sobrevivir a los antibióticos y eventualmente volverlos inoperantes. Por tal motivo, los investigadores indicaron que seguirán buscando para determinar de qué manera las bacterias usan sus impulsos eléctricos para infectar células humanas.
"Si bloqueamos la actividad eléctrica bacterial, quizá las bacterias tengan menos posibilidades de infectar", básicamente, "porque no sabrán dónde están y, por lo tanto, tampoco sabrán cómo actuar", afirmó Kralj.
LEA MÁS:
Últimas Noticias
Explosiones casi simultáneas destruyeron viviendas de dos abogados en Ecuador
La Policía investiga la modalidad empleada y no reporta detenidos hasta el momento

El corozo, fruta típica de la costa Caribe, se utiliza en dulces y jugos y posee propiedades medicinales reconocidas
Este producto se ha convertido en símbolo de identidad regional, fusionando tradición culinaria, valor nutricional y un potencial ecológico que va mucho más allá de su presencia cotidiana

San Alejandro: ¿Quién es y por qué se conmemora este 26 de febrero?
La figura del obispo destacó en el siglo IV por su acción ante la controversia doctrinal impulsada por Arrio

Colombia vs. Venezuela - EN VIVO: siga aquí el partido clave de la Tricolor por un cupo al Mundial 2026 en el Sudamericano Femenino Sub20
La Amarilla suma tan solo un punto y no tiene márgen de error en la lucha por clasificar a la Copa Mundial Femenina Sub20 de la FIFA, que se jugará en el segundo semestre del 2026 en Polonia
Popocatépetl registró 6 exhalaciones en las últimas 24 horas
Al ser un volcán activo y uno de los de mayor riesgo en todo México, el estado del Popocatépetl es de principal preocupación para pobladores de zonas vecinas en Morelos, Puebla y el Estado de México


